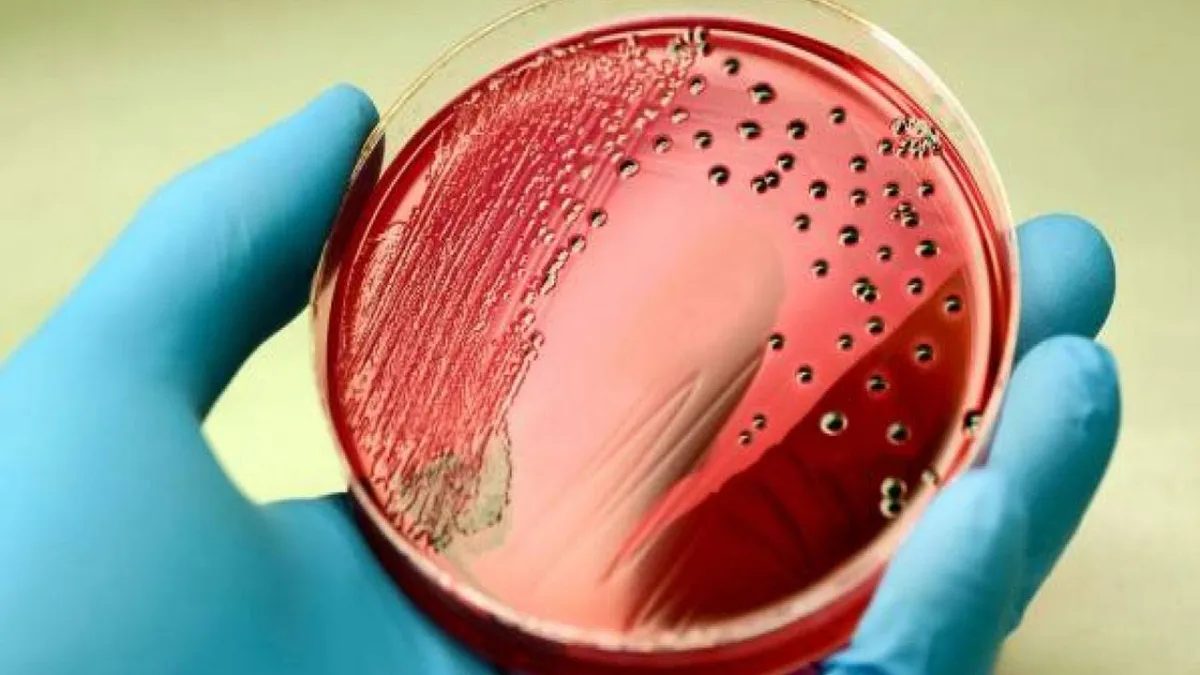
تؤثر حالة انتنان الدم على الأشخاص في أي عمر

تؤثر حالة "انتنان الدم"، أو "تعفن الدم" بحسب الخبراء والأطباء على الأشخاص في أي عمر، لكنها تعتبر أكثر خطورة على كبار السن، والنساء الحوامل، والأشخاص الذين يعانون من ضعف في جهاز المناعة، والأطفال الذين تقل أعمارهم عن عام واحد.
وفي هذا الصدد، فقد كشفت مدينة الملك فهد الطبية، عن المقصود بحالة تعرف بـ "إنتان الدم"، مشيرةً، أنها حالة تهدد الحياة إذا لم تعالج مبكراً.
وقالت المدينة، عبر حسابها الرسمي على موقع التدوينات المصغر "تويتر" في انفوغراف، إن "إنتان الدم" هي عبارة عن مواد كيميائية يطلقها الجسم في مجرى الدم لمحاربة العدوى، وتكون استجابة الجسم لها متوازنة يؤدي ذلك إلى "تعفن الدم "وهي حالة تهدد الحياة إذا لم يتم علاجها في وقت مبكر.
وأوضحت، أن أعراض "إنتان الدم" تتمثل في التالي:
- تغيُر في الحالة العقلية.
- انخفاض الضغط الانقباضي "العلوي".
- يكون معدل التنفس 22 نفساً في الدقيقة أو أعلى.
وأشارت المدينة، إلى أن هناك عوامل عديدة للإصابة بـ"إنتان الدم" منها، (الالتهاب الرئوي، عدوى الكلى والمثانة، عدوى الجهاز الهضمي، تجرثم الدم).
وأبانت مدينة الملك فهد الطبية، أنه يمكن علاج حالة "انتنان الدم" عن طريق العلاج الدوائي أو عن طريق العلاج الجراحي.
تجدر الإشارة إلى أن " لإنتان" يحدث عندما تقوم بكتريا معينة بإنتاج سمومها، مما يؤدي إلى تحرير مواد من خلايا الجسم تُسبب ردة الفعل الالتهابية، وتعرف تلك المواد باسم السيتوكينات cytokines، وعلى الرغم من أن "السيتوكينات" تساعد الجهاز المناعي على مكافحة العدوى، إلا أنها قد تُسبب آثاراً ضارة.
وغالبًا ما يموت مرضى "الصدمة الإنتانية" في حال عدم تقديم العلاج لهم، وحتى عند تقديم العلاج لهم، فإن خطر الوفاة مرتفع، حيث يتوفى ما نسبته 30-40% من مرضى "الصدمة الإنتانية"، ولكن خطر الوفاة يتباين بشكل كبير بالاعتماد على بعض العوامل، مثل سرعة تقديم العلاج، ونوع البكتريا المُسببة للصدمة (وخاصةً ما إذا كانت البكتريا مُعندة على المضادات الحيوية أم لا)، وما إذا كان المريض يشكو من حالات مرضية أخرى أم لا.

Google News
Google News 





















